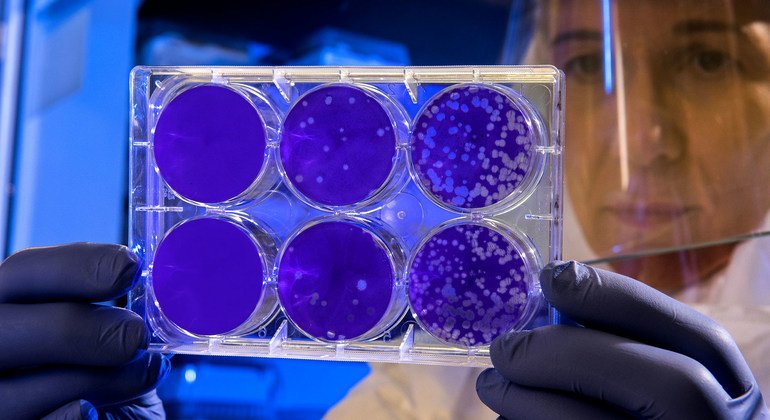
Follow the science: UN plans for a stronger pandemic recovery

Funders responsible for more than $100 million of annual global research investments joined the deputy UN chief Amina Mohammed on Friday to discuss how to unify research efforts, and use science to recover effectively from the COVID-19 pandemic.Funders responsible for more than $100 million of annual global research investments joined the deputy UN chief Amina Mohammed on Friday to discuss how to unify research efforts, and use science to recover effectively from the COVID-19 pandemic.
Follow the science: UN plans for a stronger pandemic recoveryon Gennaio 29, 2021 at 7:50 pm on Gennaio 29, 2021 at 7:50 pm on Gennaio 29, 2021 at 7:50 pm UN News – Health
Home|Breaking news|Follow the science: UN plans for a stronger pandemic recoveryon Gennaio 29, 2021 at 7:50 pm on Gennaio 29, 2021 at 7:50 pm on Gennaio 29, 2021 at 7:50 pm UN News – Health
C.N.U.
Organizzazione Intergovernativa per la tutela dei Diritti Inalienabili dell’Uomo
NEWS
CONTATTACI
59100 Prato
Penisola Italica
email: contact@u-hn.org
Top Sliding Bar
This Sliding Bar can be switched on or off in theme options, and can take any widget you throw at it or even fill it with your custom HTML Code. Its perfect for grabbing the attention of your viewers. Choose between 1, 2, 3 or 4 columns, set the background color, widget divider color, activate transparency, a top border or fully disable it on desktop and mobile.
Pagine
- aaa-Investors
- About
- Adhesion of Governments, Peoples, and Ethnic Minorities
- Admission of new members Entity-Trusts-NGOs, Fondations
- Assistance and Defense
- Become a Human Rights Observer
- Become a Volunteer – Registration Levels
- Becoming an HRD
- Case Management – SAPG Legal Office
- Classic Home
- Classic Home New
- CNU Statute
- Board Assembly Resolutions
- CNU-2025-STATUTE
- Commission for Education, Culture, Art and Sport
- Confederal High Commissioner for Human Rights (ACDU)
- Confederate Registry
- Economic and Social Policy Council
- Ethical Committee
- General Secretariat
- Humanitarian Court and Court for the Self-Determination of Peoples
- International Humanitarian Intervention Corps
- Procura CNU-ffoo
- Reserved Area
- SG202510031158-2
- Special Humanitarian Investigative Corps (C.I.U.S.)
- Universal Declaration of Natural Rights
- cnu_login
- College for the Safeguarding of the World Heritage of Wisdom
- Commission for International Relations
- Commission for Transport and Mobile Units
- Commissions
- Contact Us
- Corporate FAQ
- Corporate Governance
- Department for the Protection of Flora and Fauna
- Disaster Team
- Earnings
- Earthquakes
- Economic Council Contacts
- Economic Development
- F.A.Q. Legal Protection for CNU Human Rights Defenders
- Floods
- Foreign Diplomatic Missions
- Free Course on Emergencies – CNU-VAB Environmental Sentinels
- Freedom to Choose
- General Secretariat
- Guidance on Self-Determination
- Health and Integrated Medicine Board
- History
- Home page
- Honorary Members – Governments-Peoples-Organizations
- How We Support Global Humanitarian Work
- Human Rights – CNUHRD
- HumanBank
- Humanitarian Emergencies
- Information
- international law
- International messages
- login_block
- My Account
- My Account
- National law enforcement agencies
- Natural Disasters
- News
- Objectives
- Official Messages
- OPERATIONAL REGULATION FOR THE ADMISSION OF COLLECTIVE MEMBERS
- Our Culture
- Payment
- Peace and Security
- Permanent CNU Collection Points and Human Rights Violation Reports
- Privacy policy
- Procura CNU
- Registration Process
- Registration to the C.N.U
- Relations with EU Areas
- Relations with Non-EU Areas
- Reserved area
- Autodeterminazione Efficace Guida pratica alla trasformazione giuridica coerente degli Enti trust
- CNU Health Network
- Control Panel – CNU Registry Data
- Convezione Esercenti CNU
- Delibere Assembleari/Sondaggi membri
- Economic Development and Internal Economy
- Emergency Protocols DsT
- Ents-Services
- Foglio inserimento foto-firma-araldica
- Gestione Pratiche Studio SAPG
- Guida Operativa per Enti ad Alto Scopo Umanitario
- manuale difensore diritti umani
- Manuale Operativo per la Creazione e la Gestione di Attività Umanitarie
- plenary forum CNU
- Registration
- Secretariat – Internal Communications
- SECRETARY’S COMMUNICATION 17JUN22
- statuto-dichiarazione diritti umani-regolamenti
- Statuto-dichiarazione-manuali
- Territorialità IVA: Guida per enti extraterritoriali-con Sede ESTERA
- Territorialità IVA: Guida per enti extraterritoriali-con Sede ITALIANA
- Thank you for your donation!!!
- Useful Links
- Who We Are
- Why Become a CNU Human Rights Defender
- Work with CNU
Recent Tweets
Newsletter
Sign-up to get the latest news and update information. Don’t worry, we won’t send spam!


Scrivi un commento
Devi accedere, per commentare.